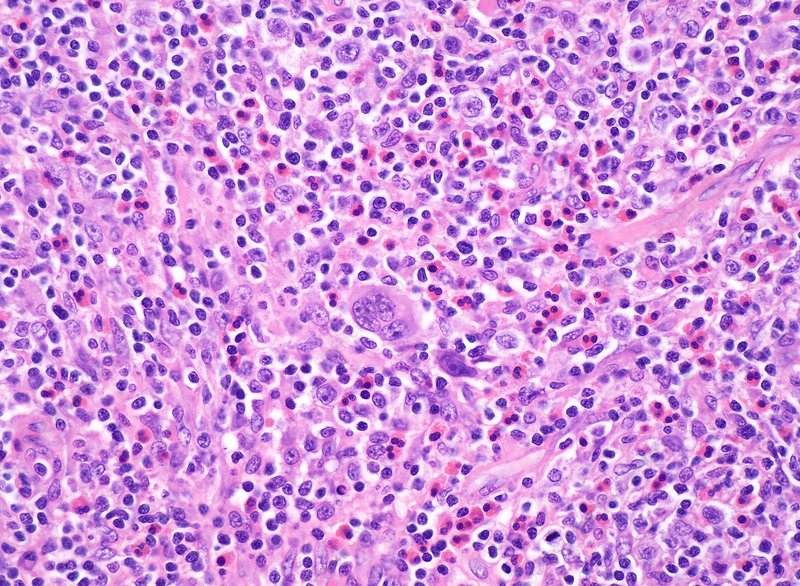

안녕하세요. 고반입니다.
(이 글은 PC버전을 기준으로 작성되었습니다)
오늘은 림프종에 대해 알아보겠습니다.

림프종이란?
림프계는 림프액을 몸 전체로 이동시키는 일련의 림프절과 혈관입니다.
림프액에는 감염과 싸우는 백혈구가 포함되어 있습니다.
림프절은 필터 역할을 하여 박테리아와 바이러스를 포획하고 파괴하여 감염이 퍼지는 것을 방지합니다.
림프계는 일반적으로 신체를 보호하지만,
림프구라고 하는 림프 세포는 암이 될 수 있습니다.
림프계에서 발생하는 악성 종양을 림프종이라고 합니다.
의사는 통상 70가지 이상의 암 유형을 림프종으로 분류 합니다.
림프종은 골수, 흉선, 비장, 편도선, 림프절을 포함하여 림프계의 모든 부분에 영향을 줄 수 있습니다.
일반적으로는 림프종을 호지킨 림프종과 비호지킨 림프종 두 가지 범주로 나눕니다.
림프종 원인
림프종의 원인은 정확히 밝혀진 것이 없습니다.
일반적으로는 유전적 요인, 바이러스, 면역체계 결핍 등을 원인으로 꼽습니다.
림프종, 암은 통제되지 않은 세포 성장의 결과입니다.
일반적으로 세포의 평균 수명은 짧고 죽습니다만,
림프종 환자의 경우 세포가 죽지 않고 번성하고 퍼집니다.
림프종 위험요인
비호지킨 림프종 위험요인
면역 결핍
인간 면역 결핍 바이러스(HIV) 또는 AID로 인한 면역 체계가 약하거나 장기 이식 후 면역 체계 억제 약물을 복용하기 때문일 수 있습니다.
자가면역질환
류마티스 관절염 및 체강 질환과 같은 특정 자가면역 질환이 있는 사람들은 림프종의 위험이 증가합니다.
나이
림프종은 60세 이상의 사람들에게 가장 흔합니다.
그러나 일부 유형은 어린이와 유아에게 더 흔합니다.
성별
여성은 특정 유형의 림프종이 발병할 가능성이 더 높고 남성은 다른 유형이 발병할 가능성이 더 높습니다.
인종
미국의 백인 미국인은 아프리카계 미국인이나 아시아계 미국인보다 일부 유형의 림프종에 걸릴 가능성이 더 높습니다.
전염병
인간 T 세포 백혈병/림프성 바이러스(HTLV-1), 헬리오박터 파일로리, C형 간염 또는 엡스타인-바 바이러스(EBV)와 같은 감염이 있는 사람은 위험 증가와 관련이 있습니다.
화학 영향 및 방사선 노출
살충제, 비료 및 제초제의 화학 물질에 노출된 사람들도 위험이 증가합니다.
핵 방사선은 NHL 발병 위험을 증가시킬 수도 있습니다.
비만
비만은 가능한 위험 요소로 림프종과 관련되어 있지만 이 가능한 위험 요소를 이해하기 위해서는 더 많은 연구가 필요합니다.
호지킨 림프종 위험 인자
나이
20세에서 30세 사이의 사람들과 55세 이상의 사람들에게서 더 많은 사례가 진단됩니다.
성별
남성은 여성보다 이러한 유형의 림프종이 발병할 가능성이 더 큽니다.
가족력
만약 형제 자매가 이러한 유형의 암으로 진단되면 본인도 암이 발병할 위험이 더 높아집니다.
전염성 단핵구증
EBV 감염은 단핵구증을 유발할 수 있습니다.
이 감염은 림프종의 위험을 증가시킬 수 있습니다.
면역 결핍
HIV 감염자는 림프종 발병 위험이 더 큽니다.

림프종 증상
림프종은 초기 단계에서 항상 증상을 일으키는 것은 아닙니다.
대신 의사는 신체 검사 중에 림프절 비대를 발견할 수 있습니다.
이들은 피부 아래에 작고 부드러운 결절처럼 느껴질 수 있습니다.
일반적으로 목, 가슴 윗부분, 겨드랑이, 위 등에서 림프절을 느낄 수 있습니다.
초기 림프종의 많은 증상은 특이하지 않습니다.
그래서 간과하기 쉽습니다.
림프종의 일반적인 초기 증상으로는,
기침, 피로, 뼈 통증, 열, 식은땀, 림프절 비대,
무력감, 가려운 발진, 호흡곤란, 피부 가려움증,
복통, 설명할 수 없는 체중 감소 등이 있습니다.
호지킨 림프종은 특히 호흡기계로 침범시에는 흉통의 가능성이 있고, 소화기계의 간과 비장에 침범하게 된다면 복부팽만, 황달 등의 증상이 발견될 수 있습니다.
비호지킨 림프종은 위장관게에 침범하게 된다면 복통, 혈변 등의 증상이 발견될 수 있습니다.
림프종의 증상은 종종 쉽게 간과되기 때문에 조기에 발견하고 진단하기 어려울 수 있습니다.
병이 악화됨에 따라 증상이 어떻게 변하기 시작하는지 아는 것이 중요할 수 있습니다.
림프종 진단
림프종을 의심하는 경우 일반적으로 혈액검사를 기본으로 실시합니다.
그리고 조직검사가 실시될 수 있습니다.
이것은 비대된 림프절에서 세포를 제거하는 것을 포함합니다.
혈액병리학자로 알려진 의사는 림프종 세포가 있는지 여부와 세포 유형을 결정하기 위해 세포를 검사할 수 있습니다.
혈액병리학자가 림프종 세포를 발견하면 추가 검사를 통해 암이 얼마나 퍼졌는지 확인할 수 있습니다.
이러한 검사에는 흉부 X선 검사, 혈액 검사 또는 주변 림프절이나 조직 검사가 포함될 수 있습니다.
컴퓨터 단층촬영(CT) 또는 자기공명영상(MRI) 스캔과 같은 영상 촬영운 또한 추가 종양 또는 확대된 림프절을 식별할 수 있습니다.
또한 골수 검사를 통해 골수에까지 침범이 있는지 여부를 확인할 수도 있습니다.
림프종 치료
비호지킨 림프종 치료
비호지킨 림프종을 치료하기 위해서는 주로 항암 화학요법을 실시합니다.
입원치료 후 통원 치료를 실시합니다.
약 3-4주의 간격으로 항암치료를 실시합니다.
우선 몇 번의 항암치료 이후에 골수 검사나 CT촬영을 통해 약물에 대한 몸의 반응을 확인하고, 만약 반응이 괜찮다면 이어서 치료를 시행합니다.
만약 이때 반응이 좋지 않게 된다면 약물을 바꾸어 새로운 치료를 실시합니다.
호지킨 림프종 치료
호지킨 림프종을 치료하기 위해서는 항암 화학요법과 방사선 치료를 실시하게 됩니다.
림프종 종류
위에서 림프종에 대한 모든 것들을 알아봤습니다.
끝내기 전에 마지막으로 림프종의 상세 종류에 대해 한 번 알아보겠습니다.
앞서 알려드렸듯이,
림프종의 주요 두 종류는 호지킨 림프종과 비호지킨 림프종이 있습니다.
이러한 림프종에는 어떤 것들이 포함되는지 아래에서 살펴보겠습니다.
비호지킨 림프종
B세포 림프종
미만성 거대 B 세포 림프종(DLBCL)은 비호지킨 림프종(NHL)의 가장 공격적인 유형입니다.
이 빠르게 성장하는 림프종은 혈액의 비정상적인 B 세포에서 비롯됩니다.
치료하면 완치될 수 있지만 치료하지 않으면 사망에 이를 수 있습니다.
DLBCL의 단계는 예후를 결정하는 데 도움이 됩니다.
T세포 림프종
T 세포 림프종은 B 세포 림프종만큼 흔하지 않습니다.
모든 비호지킨 림프종(NHL) 사례의 15%만이 이 유형입니다.
여러 유형의 T 세포 림프종이 존재합니다.
버킷 림프종
버킷 림프종은 면역 체계가 손상된 사람들에게 가장 흔하고 공격적인 비호지킨 림프종(NHL)의 드문 유형입니다.
이 유형의 림프종은 사하라 사막 이남 아프리카의 어린이에게 가장 흔하지만 세계의 다른 지역에서도 발생합니다.
여포성 림프종
미국에서 진단된 림프종의 5분의 1은 여포성 림프종이라고 알려져 있습니다.
백혈구에서 시작되는 이러한 유형의 NHL은 노인에게서 가장 흔합니다.
평균 진단 연령은 60세라고 합니다.
이 림프종도 천천히 자라므로 주의 깊게 기다리는 것으로 치료를 시작합니다.
외투 세포 림프종
이 공격적인 형태의 림프종은 드물며, 비호지킨 림프종(NHL) 사례의 약 6%만이 이 유형입니다.
외투 세포 림프종은 또한 후기 단계에서 더 일반적으로 진단되며, 일반적으로 위장관 또는 골수에서 발생하거나 이를 포함합니다.
원발성 종격동 B 세포 림프종
이 하위 유형의 B 세포 림프종은 DLBCL 사례의미만성 거대 B 세포 림프종(DLBCL) 거의 10%를 차지합니다.
주로 20~30대 여성에게 많이 발생합니다.
소림프구성 림프종
소림프 림프종(SLL)은 천천히 자라는 림프종의 일종입니다.
SLL의 암세포는 대부분 림프절에서 발견됩니다.
SLL은 만성 림프구성 백혈병(CLL)과 동일하지만 CLL의 경우 대부분의 암세포가 혈액과 골수에서 발견됩니다.
림프형질구성 림프종
림프형질구성 림프종(LPL)은 약 1~2%를 차지하는 드문 유형입니다.
주로 노인들에게 영향을 미칩니다.
발덴스트롬 거대글로불린혈증은 LPL의 아형입니다.
비정상적인 항체 생성을 유발합니다.
호지킨 림프종
림프구 결핍 호지킨병
이 희귀하고 공격적인 유형의 림프종은 림프종 사례의 약 1%에서 발생 하며 30대에서 가장 흔하게 진단됩니다.
진단 테스트에서 의사는 RS세포가 풍부한 정상 림프구를 볼 수 있습니다.
HIV 감염자와 같이 면역 체계가 손상된 환자는 이러한 유형의 림프종으로 진단될 가능성이 더 높습니다.
림프구 풍부 호지킨병
이 유형의 림프종은 남성에게 더 흔하며 호지킨 림프종 사례의 약 5%를 차지합니다.
림프구가 풍부한 호지킨병은 일반적으로 초기 단계에서 진단되며 림프구와 RS 세포 모두 진단 테스트에 존재합니다.
혼합 세포성 호지킨 림프종
림프구가 풍부한 호지킨병과 마찬가지로 혼합 세포성 호지킨 림프종은 림프구와 RS 세포를 모두 포함합니다.
호지킨 림프종의 거의 4분의 1이 이 유형이며, 노인 남성에게 더 많이 발생합니다.
결절성 림프구 우세 호지킨병
결절성 림프구 우세 호지킨병(NLPHL) 유형의 호지킨 림프종은 림프종 환자의 약 5%에서 발생하며 RS세포가 없는 것이 특징입니다.
NLPHL은 30세에서 50세 사이의 사람들에게 가장 흔하며 남성에게 더 흔합니다.
드물게 NLPHL이 진행되거나 공격적인 NHL 유형으로 변형될 수 있습니다.
결절성 경화증 호지킨 림프종
이 흔한 유형의 림프종은 호지킨의 경우의 70%에서 발생하며 다른 어떤 그룹보다 젊은 성인에서 더 흔합니다.
이 유형의 림프종은 흉터 조직 또는 경화증을 포함하는 림프절에서 발생합니다.
다행히도 이러한 유형의 림프종은 높은 치료율로 치료가 가능합니다.
림프종 예방
과격한 운동이 아닌 적절한 걷기나 스트레칭, 체조 등의 운동을 규칙적으로 실시하는 것이 좋고, 이를 통해 체중관리를 실시하는 것이 도움이 될 수 있습니다.
또한, 높은 콜레스테롤 수치의 음식을 피하고 이러한 생활습관을 들이는 것이 중요합니다.
또한 흡연을 하지 않는 것이 필요합니다.
자, 이렇게 오늘은 림프종에 대한 모든 것을 알아봤습니다.
림프종이 다소 낯선 분들도 이를 통해 많은 것을 알아가셨으리라 생각됩니다.
오늘도 이 정보가 많은 도움이 되었길 바라며,
저는 이만 글을 마치도록 하겠습니다.
끝까지 읽어주셔서 감사합니다.
'건강 정보 > 질병 백과' 카테고리의 다른 글
| 지방종 알려드립니다. 지방종에 대한 모든 것. (0) | 2021.11.13 |
|---|---|
| 동상에 대한 모든 것 알려드립니다. (0) | 2021.11.12 |
| 티눈과 굳은살에 대해 알려드립니다. 티눈 굳은살에 대한 모든 것! (0) | 2021.11.03 |
| 볼거리 증상 알려드립니다. 볼거리에 대한 모든 것! (0) | 2021.09.20 |
| 장폐색 증상 알려드립니다. 장폐색에 대한 모든 것. (0) | 2021.09.15 |